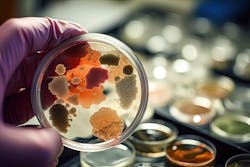

Legrand Adds Microban-Protected Devices and Wall Plates to their radiant Collection
WEST HARTFORD, Conn — Legrand, a world-renowned specialist in electrical wiring devices, has leveraged their exclusive partnership with Microban, the global leader in antimicrobial and odor control solutions, to add a selection of antimicrobial switches, dimmers and wall plates to their radiant Collection of designer devices.
Integrated at the time of manufacturing, the Microban antimicrobial product protection will continuously work at the cellular level to inhibit the growth and reproduction of bacteria, including strains which can cause staining, odor and premature degradation. Unlike topical or spray alternatives that need to be reapplied, the built-in Microban protection is designed to work 24/7, 365, for the entire lifetime of the product, so that devices are both 99.9% cleaner and more durable.
“Studies have shown that light switches, especially in areas like bathrooms and kitchens, are some of the dirtiest surfaces in a home,” comments Scott Bausch, VP and General Manager at Legrand. “But by working with the experts at Microban, we’re giving our customers one easy way to create and maintain cleaner spaces, while still delivering the elevated style and functionality they expect from our designer Collections.”
The eight new radiant products—which feature the antimicrobial product protection on several of the Collection’s most popular lighting controls and wall plates—extends Legrand’s offering for cleaner control to create cleaner spaces, which includes touchless and smart controlled devices as well as a broad selection of antimicrobial switches, dimmers and wall plates from Legrand’s adorne Collection. At this time, the antimicrobial devices from both the radiant and adorne Collections are available in the US only.
###